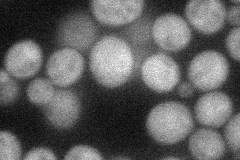
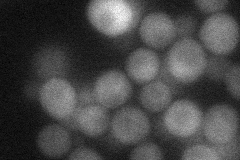
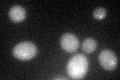
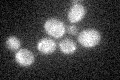
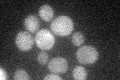

View description
Serine-rich, hydrophilic protein with similarity to Mbr1p; overexpression suppresses growth defects of hap2, hap3, and hap4 mutants; expression is under glucose control; cotranscribed with NAM7 in a cyp1 mutant
Localization:
Intensity:
Fold change:
Significance:
-
C’ GFP library in SD

cytosol21.71 -
N' NOP1pr-GFP in SD
cytosol36.3061 -
N' TEF2pr-mCherry in SD
cytosol28.0278 -
N' NATIVEpr-GFP in SD

below threshold20.2182 -
N' TEF2pr-VC and Cyto-VN in SD

vacuole membrane29.5275 -
C’ GFP library in SD+DTT
cytosol23.411.07No -
C’ GFP library in SD+H2O2
cytosol19.40.89No -
C’ GFP library in Starvation Media
cytosol32.911.51No -
C’ GFP library on the background of Pup2-DaMP

cytosol -
C’ GFP library on the background of CCT mutant

cytosol26.38491.21478No
